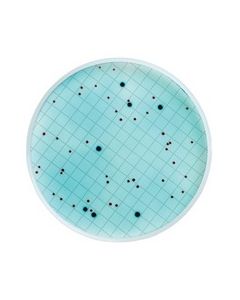
MHA000P2F.jpg
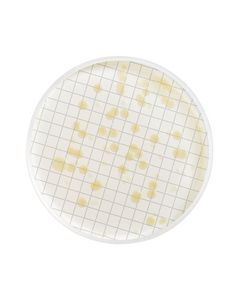
MHA000P2S.jpg

The store will not work correctly when cookies are disabled.
- Termos de pesquisa relacionados
-
millipore
-
filtracao polissulfona nalgene 47mm
-
filtracao polissulfon nalgene 47mm
-
filtracao polisulfon nalgene 47mm
-
filtracao polisulfona nalgene 47mm

ANEL VEDACAO EM VITON PARA CILINDRO EXTRATOR ZHE MILLIPORE - 03 N
Modelo: XX6700010
R$ 1.572,80

FRASCO 1000ml C/ ROLHA EM NEOPRENE P/ DISPENSADOR DE SOLVENTE MILLIPORE
Modelo: XX6602501
R$ 2.544,52

ANEL VEDACAO PARA PISTAO E SELO DO EXTRATOR ZHE (UND) MILLIPORE
Modelo: YT3009003
R$ 769,79

MEIO M FC EM AMPOLA 2ml PARA COLIFORMES FECAIS (CX) MILLIPORE
Modelo: MHA000P2F
R$ 886,75

MEIO HPC/SPC EM AMPOLA 2ml PARA BACTERIAS TOTAIS (CX) MILLIPORE
Modelo: MHA000P2S
R$ 889,94

TAMPA E AGULHA DA VALVULA DE AMOSTRAGEM MILLIPORE (CX/ 05 UND)
Modelo: MXPESP5CN
R$ 241,42

VALVULA DE 3 VIAS 1/4 NPTM FEMEA LUER (EMB) MILLIPORE
Modelo: XX2504702
R$ 3.184,67

MEMBRANA MISTURA ESTER CELULOSE IMMOBILON 0,45um ROLO 33 X 300cm MILLIPORE
Modelo: HATF00010
R$ 4.376,50

MEMBRANA BIOMAX DE ALTO FLUXO DIAM. 63,5mm PORO 300KD (CX) MILLIPORE
Modelo: PBMK06210
R$ 1.158,61

KIT PECAS REPOSICAO HYDROSOL INSERC. CHAVES, JUNTA, GAXETAS DE TEFLON - MILLIPORE
Modelo: XX20047RK
R$ 3.097,13

CENTRICON PLUS 70 COM MEMBRANA CELULOSE REGENERADA ULTRACEL 30kDa (CX) MILLIPORE
Modelo: UFC703008
R$ 2.295,62

CARTAO ABSORVENTE TIPO AP10 (PAD) CELULOSE DIAM 25mm MILLIPORE - 100 UND
Modelo: AP1002500
R$ 432,61